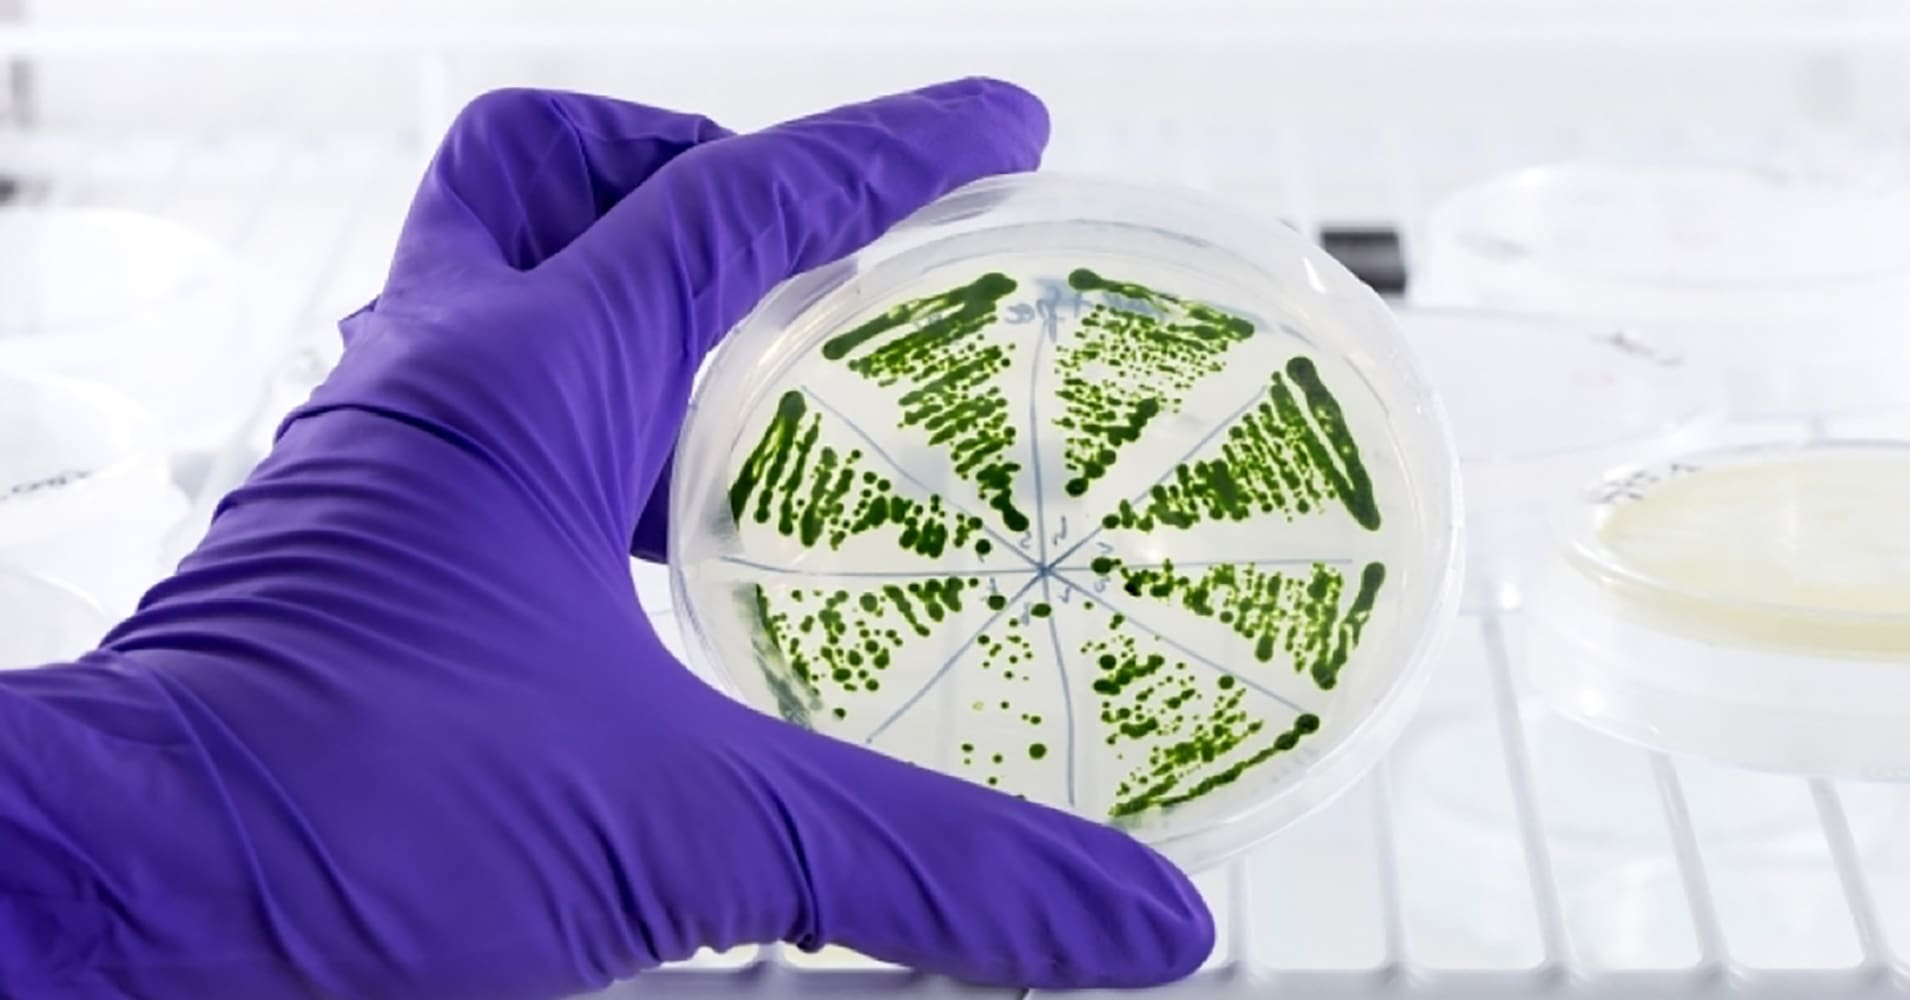
新方法利用微藻制造環保碳纖維

碳纖維增強聚合物復合材料(CFRP)憑借其輕量化與高強度特性,已成為航空航天結構設計的核心材料,顯著提升了飛行器的燃油效率與綜合性能。本文基于權威文獻分析,系統梳理CFR...

2025年9月4- 6日,中國復合材料工業協會將在浙江紹興舉辦“第七屆碳纖維復合材料產業創新發展大會”。本次大會匯聚了碳纖維復合材料領域的眾多行業精英,他們將帶來精彩紛呈的...

當科技浪潮奔涌向前,新材料是定義未來的關鍵力量。碳纖維復合材料,這一被譽為“新材料之王”的戰略性材料,正以其無與倫比的性能優勢,深刻重塑著航空航天、新能源、高端裝...

由中國復合材料工業協會主辦的“第七屆碳纖維復合材料產業創新發展大會暨專委會換屆工作會”定于9月4-6日在浙江紹興柯橋區召開,為何本屆大會,最終選擇了浙江紹興柯橋區?答...

摘要:今年8月,GB/T 41762.1-2025《纖維增強塑料復合材料層合板厚度方向性能的測定第1部分:直接拉伸和壓縮試驗》正式發布,結合GB/T 41762.2-2025《纖維增強塑料復合材料...

Engel-恩格爾(奧地利施韋特貝格)推出高效輕量化設計解決方案,使得生產時間大幅縮短,并顯著減少材料用量。在2025年德國橡塑展(K 2025)上,恩格爾公司將展示其創新的注塑...
碳纖維在航空、風能和輕型建筑領域發揮著至關重要的作用。然而,傳統的碳纖維生產依賴于石油衍生材料,對環境造成了顯著影響。由慕尼黑工業大學(TUM)牽頭的一個研究聯盟開發...

摘要:8月3日,中國海油、中信海直及峰飛航空聯合宣布峰飛航空2噸級eVTOL“凱瑞鷗”成功完成全球首次海上石油平臺物資運輸飛行。這一突破創新了遠海物資補給模式,標志著我國...

美情報機構頻繁對我國防軍工領域實施網絡攻擊竊密國家互聯網應急中心(CNCERT)監測發現,近年來,美國情報機構將網絡攻擊竊密的重點目標瞄準我高科技軍工類的高校、科研院所...

在全球環保法規日益嚴苛的大背景下,汽車行業面臨著制造低排放或零排放汽車的緊迫需求,這直接推動了對輕量化、可持續材料及先進制造工藝的強烈渴望,汽車復合材料市場由此迎...
點擊排行
- 107-07中國復合材料工業協會會費繳納標準及管理辦法
- 206-12一文帶你了解復合材料:復合材料的種類、加工及應用
- 312-07高性能纖維——芳綸纖維(概述篇)
- 410-12 【最新政策】對中國免簽的國家!
- 501-29一文了解超高分子量聚乙烯纖維(上篇)
- 603-14100個大型招標采購平臺網址匯總,建議收藏!(上)
- 710-29聚焦聚酰亞胺:聚酰亞胺纖維、復合材料性能優異,前景廣闊(一)
- 802-27超高分子量聚乙烯(UHMWPE)材料的最新應用與未來展望
- 911-28無人機發展現狀及未來展望(下篇)
- 1007-06協會介紹
最近更新
- 10-17【年會定檔】家宴已備 共話未來 | 2025年復合材料行業年會暨協會換屆大會
- 09-252026年3月丨法國JEC展覽會:中國復合材料行業協會邀您共赴行業盛會
- 11-14【會員風采】東弘中纖(廈門)先進結構材料研究院有限公司
- 11-142026年3月 | 鎖定JEC核心!2026年,我們在6號館等您!
- 11-14展商風采 | 河南省菲優特過濾設備有限公司——2025復合材料行業年會
- 11-14復合材料在新能源領域的應用與性能優化研究進展
- 11-14展商風采 | 新陽科技集團有限公司——2025復合材料行業年會
- 11-14中東歐經濟韌性與復合材料市場發展專題分析
- 11-14世索科集團(Syensqo)與貝爾公司(Bell)攜手合作,推動復合材料部件制造產業化進程
- 11-14山東金利德機械股份有限公司——2025復合材料行業年會